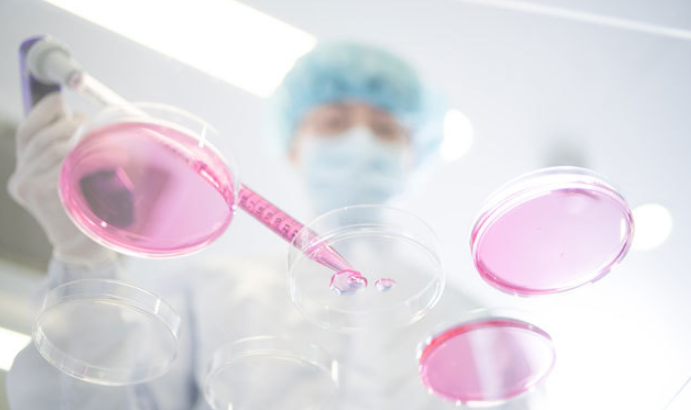

올해 기업공개(IPO) 시장이 연초부터 기대감에 부풀었다.
SK바이오팜을 비롯해 호텔롯데, 카카오뱅크, 현대카드 등 역대급 대어들의 등장이 예상되면서 시장이 활기를 띨 전망이다.
21일 업계에 따르면 지난해 신규 상장기업들의 공모금액은 3조5000억원 수준으로 2018년 대비 약 25% 증가했다. 올해는 작년의 두 배가 넘는 8조에서 최대 10조원 규모도 가능할 것으로 예상된다.
SK증권 나승두 연구원은 “SK바이오팜, 카카오뱅크, 크래프톤 등 대어급 기업의 예상 시가총액을 합하면 18조~20조원에 달한다”며 “시총의 약 20%만 공모가 진행된다 하더라도 약 8조원 수준”이라고 말했다.
이어 “여기에 호텔롯데의 재상장이 추진된다면 올해 총 공모금액 규모는 훨씬 커질 가능성이 높다”고 덧붙였다.
한국거래소 기업공시채널(KIND)에 따르면 지난해 하반기부터 현재까지(2019년 7월 1일~2020년 1월 20일) 거래소에 상장 예비심사청구서를 제출하고 상장절차를 밟고 있는 기업은 23곳(코스피·코스닥 포함)이다.
올해 초에는 ▲위세아이텍 ▲서남 ▲화장품 소재기업 엔에프씨 ▲강화유리 전문기업 제이엔티씨 ▲나노 소재업체 레몬 ▲항공기 부품업체 켄코아에어로스페이스 ▲건축 시공업체 센코어테크 등이 잇따라 증권신고서를 제출하고 IPO 시장에 도전했다.
특히 올 상반기 기대되는 대어급은 SK바이오팜이다.
이 회사는 지난해 11월 독자 개발한 뇌전증 치료 신약 ‘엑스코프리(성분명 세노바메이트)’가 미국 FDA(식품의약국) 판매 허가를 받으면서 제약·바이오업계에서 기대가 높은 곳이다. 기업가치 5조원 이상, 공모금액만 1조원이 넘을 것으로 예상된다.
5년 만에 상장 재도전에 나서는 호텔롯데에 대한 관심도 뜨겁다.
최근 롯데그룹은 호텔롯데 상장을 진두지휘한 송용덕 롯데지주 부회장을 지주 공동대표로 선임하는 한편 이봉철 롯데 사장을 호텔&서비스BU(Business Unit)장에 앉힌 등 호텔롯데 IPO에 대한 의지를 드러내고 있다.
호텔롯데의 기업가치는 10조원 이상에 공모금액도 4조~5조원에 달할 것으로 기대된다.
2조원 이상의 기업가치가 예상되는 카카오뱅크도 올 하반기를 목표로 상장을 추진 중이다.
IPO를 통해 자본을 확충하고 이를 바탕으로 사업 영역을 확장해 기존 은행과 본격적인 경쟁에 나서겠다는 계획이다.
이들 기업들은 2018~2019년 유가증권시장에서 대어가 없었던 갈증을 올해 해소해 줄 것으로 기대된다.
[사진제공=뉴시스]

